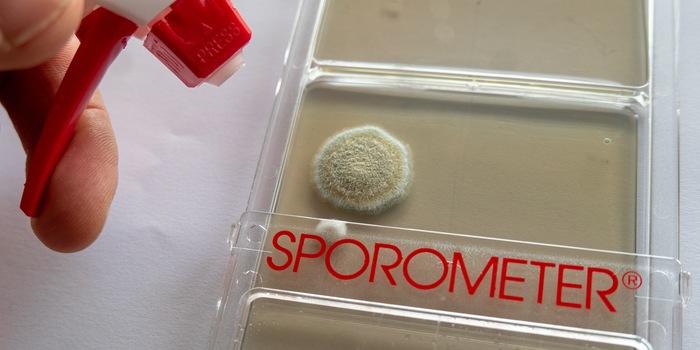

Schimmel im Schlafzimmer? Sporensuche mit Kommissar Mellerud

Schimmel ist sch… ädlich. Das Thema verfolgt mich schon ein paar Jahre und ich bin nicht sicher, ob ich den Kampf irgendwann gewinne. Der Schnelltest von Mellerud soll neue Hinweise liefern.
«Hat jemand ein Schimmel-Problem und will darüber schreiben?» Als die Frage in unserem Redaktionschat aufpoppt, wandern meine Gedanken ins Schlafzimmer. Kühle Aussenwände, alte Holzfenster, chronisch hohe Luftfeuchtigkeit, die vom Garten aus durch alle Ritzen dringt. Im Herbst und Winter kann ich die Scheiben gar nicht so schnell trocken wischen, wie sich Kondenswasser bildet.
Rund um die Fenster und in den Ecken habe ich schon Schimmelspuren bekämpft. Aber ich bin mir nicht sicher, ob ich das Problem im Griff habe, weiss nicht, was hinter den Schränken und der Fussleiste lauert. Deshalb melde ich mich: «Hier! Schimmelverdacht!»
Ein paar Tage später bekomme ich ein Testpaket von Mellerud. Es enthält einen chlorfreien Schimmelentferner, der Sporen, Stockflecken und all das eklige Zeugs entfernen soll. Dazu gibt es allerlei Infos zum Thema und vor allem: einen Schnelltest. Er soll mir sagen, wie gross mein Problem ist und ob ich handeln muss. Seit meinem letzten Yps-Heft war ich nicht mehr so gespannt auf ein Gimmick.
Keine Panik, keine zu hohen Erwartungen
Schimmelpilze können krank machen. Hintergründe dazu findest du zum Beispiel in der Publikation Vorsicht Schimmel des BAG oder im Schimmel-Leitfaden des deutschen Bundesumweltamtes. Darüber hinaus kannst du im Netz allerhand Gruseliges lesen, das ich hier nicht auflisten werde. Vieles davon sei übertrieben, schreibt SRF «Puls». Unstrittig ist: Wenn er in der Wohnung wuchert, muss Schimmel entfernt werden. Und es wäre blauäugig, bei der Analyse und Ursachenforschung voll auf eine kleine Plastikschale zu vertrauen.
Ohne Ortsbegehung – beispielsweise nur nach vom Nutzer durchgeführten Do-it-Yourself-Messungen (Schimmel-Schnelltestkits, die man selber auslegt) – ist eine fachgerechte Beurteilung eines Schimmelbefalls grundsätzlich nicht möglich.
Was erwarte ich mir also? Zumindest erste Hinweise über die Qualität der Raumluft. Mehr verspricht der Schnelltest auch nicht. Er soll darüber Auskunft geben, ob das, was durch den Raum schwirrt, bedenklich ist. Sollte das der Fall sein, kann ich mir über weitere Schritte Gedanken machen.
Zunächst einmal versetzt mich der Schnelltest 25 Jahre zurück in den Biologieunterricht. Seither hatte ich nichts mehr mit Petrischalen und ähnlichen Sachen zu tun, nun starte ich mit dem «Sporometer» einen relativ einfachen Versuch. Dafür öffne ich die sterile Verpackung und nehme die rechteckige Kunststoffbox mit ihren zwei Testflächen heraus, die jeweils durch ein Fadenkreuz in vier Abschnitte geteilt werden.

Sie wird im Zimmer platziert und vorsichtig aufgeschoben, ansonsten nicht angefasst. Ich entferne mich auf Zehenspitzen und lasse sie, streng nach Anleitung, genau 30 Minuten lang offen im geschlossenen Raum stehen. Anschliessend schleiche ich mich erneut an und schiebe sie behutsam wieder zu, denn jeder Luftzug kann das Ergebnis verfälschen. Das Sporometer wandert zurück in seinen Karton und kommt auf den Schrank. Fünf Tage später werde ich wissen, was auf den Testflächen gelandet ist. Der Schimmel wird wachsen, Kolonien bilden und mir hoffentlich keinen Schrecken einjagen.
Anti-Schimmel-Basics
In der Zwischenzeit vergewissere ich mich, ob ich vorbeugend noch mehr als bisher tun kann, und lese mich durch die Infos, die ich zum Testpaket erhalten habe. Im Grunde sind es Basics, die du kennen und beherzigen solltest.
- Mehrmals täglich Stosslüften, statt Fenster dauerhaft zu kippen oder gar nicht zu öffnen. Check. So schlau bin ich inzwischen.
- Räume nicht komplett auskühlen lassen, da kalte Wände feucht werden und Schimmel ideale Bedingungen findet. Check. Lieber Stosslüften und moderat heizen, als Schimmel zu züchten.
- Luftfeuchtigkeit zwischen 40 und 60 Prozent halten. Daran arbeite ich. Dafür sorgt eine gewisse Grundwärme und im Schlafzimmer läuft stundenlang mein Luftentfeuchter. Ausserdem sind alle Räume mit einem Hygrometer ausgestattet.

- Möbel nicht zu nah an die Wand stellen. Mindestens fünf Zentimeter Abstand, bei Aussenwänden und massiven Schränken mehr. Die Luft muss zirkulieren können. Das ist unter Umständen gar nicht so einfach, denn mein Ikea-Wohntraum will zum Beispiel an die Wand gedübelt sein. Für mich nicht optimal. Für Schimmel schon.
Viel habe ich mir nicht vorzuwerfen. Doch wie sieht das «Sporometer» nach fünf Tagen aus? Mal sehen, was Kommissar Mellerud ermittelt hat. Ich erwarte keine gerichtsfesten Beweise, aber Indizien.
Wenig Infos, besseres Gefühl
Ich bin auf das Schlimmste gefasst, als ich den Schnelltest nach der Inkubationszeit wieder aus der Verpackung ziehe. Vor meinem geistigen Auge sehe ich massenhaft Schimmelkolonien. Das Schlafzimmer wird zur Sperrzone, ich richte mich auf Nächte im Wohnzimmer ein. Dann erst schaue ich hin – und der erste Blick ist erleichternd. Sieht gar nicht so schlimm aus. Nun muss ich Schimmelkolonien zählen, die sich auf den Testflächen gebildet haben. Grössere und kleinere flauschige Haufen, filzig-weiss, die munter dort wachsen, wo vor fünf Tagen die entsprechenden Sporen gelandet sind. Geringe Mengen sind normal, bei einer grösseren Anzahl wird es kritisch.

Ich zähle bis fünf. Die Anzahl der Kolonien ist überraschend klein und noch im grünen Bereich. Die beiliegende Richtwerttabelle gibt an, dass die Belastung bei einer Keimzahl von weniger als 10 unbedenklich, zwischen 10 und 16 erhöht und darüber bedenklich ist. Was genau ich da gezüchtet habe, verrät die Anleitung nicht. Zwar sind darin verschiedene Kolonien abgebildet und ich erkenne einen Typ wieder, doch eine Erklärung bleibt aus. Nicht mal ein Name steht daneben, mit dem ich mich in Panik googeln könnte.
Ich weiss nur, dass mich das Ergebnis etwas beruhigt: So schlimm wie befürchtet kann es nicht sein, laut Test ist die Sporenkonzentration in der Luft kein Problem. Um mehr zu erfahren, könnte ich das Sporometer einschicken und im Labor auswerten lassen. Für 84 Euro gibt es die Analyse, die sich in meinem Fall nicht lohnt. Ich muss nicht wissen, ob es sich bei den wenigen Sporen-Spuren um Rhizopus oryzae, Aspergillus oder Scopulariopsis handelt. Wenn die Testfelder mit Kolonien übersät gewesen wären, hätte ich eine Beurteilung vor Ort vorgezogen, statt auf dieser Basis eine mikrobiologischen Analyse mit Laborbericht zum Gefährdungspotential in Auftrag zu geben.
Der Kampf geht weiter

Trotzdem kommt der Schimmelentferner zum Einsatz. Einerseits, um der Besiedlung des Sporometers ein Ende zu bereiten, wie es mir die Anleitung befielt. Andererseits nutze ich die chlorfreie Flüssigkeit, um mir meine Fensterrahmen vorzunehmen. Der Entferner ist für sensible Bereiche und saugende Untergründe geeignet, er soll zum Beispiel auf Holz und Tapete, im Schlafzimmer oder Kinderzimmer funktionieren und unbedenklich sein. Er wird, wie bei Produkten dieser Art üblich, aufgesprüht und muss mindestens 15 Minuten einwirken. Bei starkem Befall auch mal über Nacht. Danach werden die Rückstände mit einem Tuch oder Schwamm und behandschuhten Händen abgewischt. Auf Nimmerwiedersehen wäre schön – doch die nächste Schimmeljagd kommt bestimmt. So sicher wie der nasskalte Herbst in Zürich. Was vom Schnelltest bleibt? Zumindest ein etwas besseres Gefühl.


Einfacher Schreiber, zweifacher Papi. Ist gerne in Bewegung, hangelt sich durch den Familienalltag, jongliert mit mehreren Bällen und lässt ab und zu etwas fallen. Einen Ball. Oder eine Bemerkung. Oder beides.